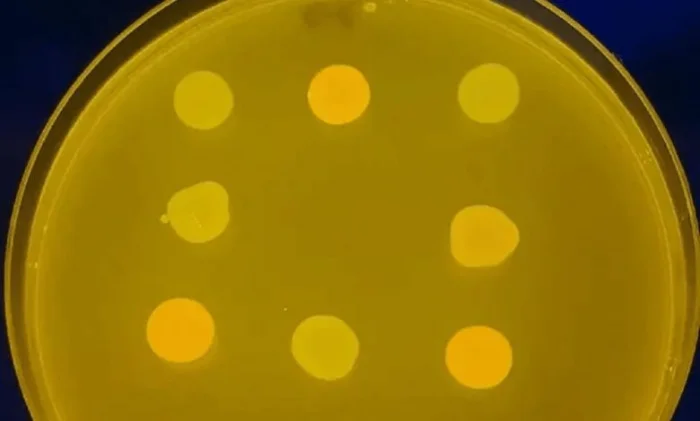
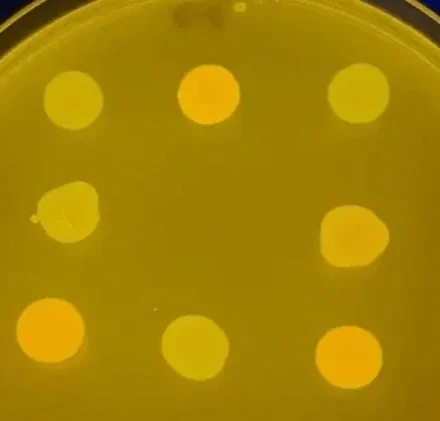

Телескоп IXPE рассмотрел остатки самой яркой сверхновой в истории
Изображение остатка сверхновой SN 1006, совмещающее данные IXPE и рентгеновской обсерватории Chandra. Данные IXPE, измеряющие поляризацию рентгеновского излучения, показаны фиолетовым цветом в левом верхнем углу, а линии отражают движение магнитного…
Читать далееСамые ожидаемые космические миссии 2020 года
Миссии на Марс и Луну или даже возвращение инопланетных образцов, у нас будет много причин для страсти к космонавтике в 2020 году. Вот самые ожидаемые миссии. К луне Артемида 1 , пожалуй, одна из самых захватывающих миссий на следующий год. Это первый из…
Читать далееДревняя египетская обсерватория возрастом 2500 лет найдена археологами
Во время раскопок в древнем городе Кафр-эш-Шейх (ныне Телль-эль-Фараин) египтологи обнаружили гигантскую астрономическую обсерваторию, датируемую IV веком до нашей эры. Она занимает площадь более 850 квадратных метров и является самой большой и древней в…
Читать далееКитай провёл новый запуск экспериментального многоразового корабля
Китай продолжает развитие собственной программы многоразовых космических кораблей, осуществив очередной запуск экспериментального аппарата. Этот шаг укрепляет позиции Китая в области орбитальных систем многократного использования, составляющих тихую, но…
Читать далееКомета из другой системы подлетела максимально близко к Солнцу
Сегодня, 29 октября 2025 года, в 13:44 по московскому времени межзвёздная комета 3I/ATLAS достигнет перигелия, то есть точки максимального сближения с Солнцем. Она окажется на расстоянии 203 миллионов км от нашей звезды, что примерно равно 1,36…
Читать далееГало Андромеды и Млечного Пути начали соприкасаться
Исследователи, использующие телескоп Хаббла, подробно описали размер и структуру ореола, окружающего галактику Андромеды. Они обнаружили, что он уже столкнулся с Млечным Путем. Вокруг большинства галактик образуется огромная сферическая оболочка из газа…
Читать далееЛишайник выжил в марсианских условиях: эксперимент приближает поиски жизни на Марсе
На Марсе может существовать жизнь — даже в его нынешнем состоянии, утверждают польские исследователи, продемонстрировавшие выживание лишайника в условиях, похожих на марсианские. Даже при воздействии ионизирующей радиации, подобной той, что бомбардирует…
Читать далееPerseverance научился самостоятельно определять координаты на Марсе
Марсоход NASA Perseverance впервые научился самостоятельно и с высокой точностью определять своё местоположение на поверхности Красной планеты, не полагаясь на помощь с Земли. Это стало возможным благодаря внедрению новой технологии под названием Mars…
Читать далееСпектрограф GHOST открывает новую эру в изучении звезд
На телескопе Gemini South, управляемом NOIRLab, установлен спектрограф высокого разрешения GHOST. Недавно он наблюдал свою первую звезду, яркую и химически сложную, и будет доступен для научных исследований с 2023 года. Недавно телескоп Gemini South в…
Читать далееАстрономы нашли одну из древнейших звезд нашей галактики
По мнению большинства астрономов, вселенная родилась из так называемого «Большого взрыва». Это произошло примерно 13,8 миллиардов лет назад, после чего последовал период расширения и охлаждения. Тогда первые атомы водорода образовали протоны и электроны,…
Читать далееТелескоп имени Нэнси Роман: сборка завершена, начинается охота за тайнами Вселенной
Строительство космического телескопа NASA «Нэнси Грейс Роман» официально завершено. Агентство сообщило 4 декабря 2025 года, что 25 ноября технические специалисты собрали внутреннюю и внешнюю секции обсерватории в самой большой чистой комнате Космического…
Читать далееРазгадана тайна ускорения межзвездной кометы ATLAS
Исследование, проведенное астрофизиком Флорианом Нойкартом, показало, что негравитационное ускорение, зафиксированное у межзвездной кометы 3I/ATLAS, может быть полностью объяснено обычной сублимацией летучих веществ, в первую очередь угарного газа (CO).…
Читать далееСоюзные программы: Россия и Беларусь расширяют сотрудничество в космосе
Глава Роскосмоса Юрий Борисов заявил о значительном укреплении космического сотрудничества с Белоруссией. На торжественной церемонии в дипмиссии Белоруссии в Москве он отметил успехи первого белорусского космонавта Марины Василевской, а также поделился…
Читать далееКосмические амбиции Индии: Луна, Венера и своя станция
18 сентября премьер-министр Индии Шри Нарендра Моди объявил о следующих четырех амбициозных космических планах страны. Индийское правительство одобрило финансирование будущих космических миссий, предложенных Индийским космическим агентством (ISRO) под…
Читать далее